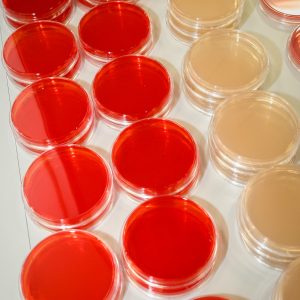

Mikrobiologi är läran om mikroorganismer. Mikroorganismer finns överallt, på, såväl som inuti oss människor, i den omgivande luften, på marken etcetera. I många verksamheter är mikroorganismerna ansedda som en förorening, dvs de kan påverka en produkt, process, personalen eller den som ska använda produkten negativt. För verksamheter med förhöjda krav på renhet och hygien spelar mikrobiologin en avgörande roll. Mikroorganismer måste kunna detekteras och bestämmas. De måste kunna styras och kontrolleras, till exempel genom rengöring, desinfektion och sterilisering.